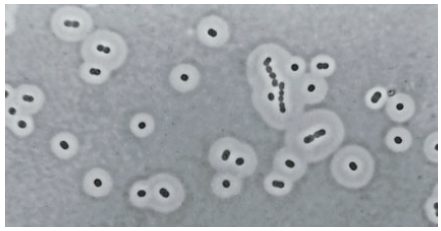
Capsules of Acinetobacter species as seen under phase-contrast microscopy after negative staining - Capsules ofAcinetobacterspecies as seen under phase-contrast microscopy after negative staining (Image source: Elliot Juni)
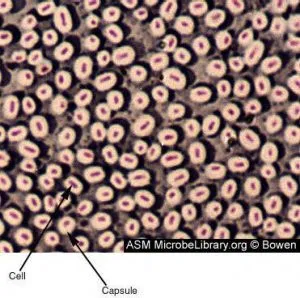
Bacterial Capsule Image source: ASM - Bacterial Capsule

Some bacterial cells are surrounded by a viscous substance forming a covering layer or envelope around the cell wall, called a capsule. Bacterial capsules can be visualized by light microscopy using special staining methods. If the layer is too thin to be seen by light microscopy, it is termed a microcapsule. It is called the slime layer if it is so abundant that many cells are embedded in a common matrix.
Capsule (also known as K antigen) is a major virulence factor of bacteria. The principal pathogens that cause pneumonia and meningitis include Streptococcus pneumoniae, Haemophilus influenzae, Neisseria meningitidis, Klebsiella pneumoniae, Â Escherichia coli, and group B streptococci have polysaccharide capsules on their surface. Nonencapsulated mutants of these organisms are avirulent.
Structure and Composition
Capsule is agelatinous layer covering the entire bacterium. In light microscopy, capsules appear to be amorphous gelatinous areas surrounding the cell. Capsule is located immediately exterior to the murein (peptidoglycan)Â layer of gram-positive bacteria and the outer membrane (Lipopolysaccharide layer) of gram-negative bacteria. In electron microscopy, the capsule appears like a mesh or network of fine strands.
Most bacterial capsules are polysaccharides (i.e. poly: many, saccharide: sugar). These polymers are composed of repeating oligosaccharide units of two to four monosaccharides. Capsules composed of single kinds of sugars are termed homopolysaccharides. For example, the capsule ofStreptococcus mutansis made up of glucose polymers. If several kinds of sugars are present in a capsule, then it is called heteropolysaccharides, eg., the capsule of *Klebsiella pneumoniae.*The capsule of Bacillus anthracis is an exception; this polypeptide capsule is composed of polymerized D-glutamic acid.
The sugar components of polysaccharides vary within the species of bacteria, which determines their serologic types. Example: Streptococcus pneumoniae has 84 different serotypes discovered so far.
Based on their composition, capsules are of three types: homopolysaccharides, heteropolysaccharides, and polypeptides.
- Homopolysaccharides: Capsules made up of a single kind of sugar. E.g., Streptococcus mutans
- **Heteropolysaccharides:**Capsules are made up of several types of sugars. E.g., Klebsiella pneumoniae
- Polypeptides: Capsules are made up of a long chain of amino acids. E.g., Bacillus anthracis **
Capsule Vs. Slime Layers
Slime is a loose network of polymers extending outward from a cell, whereas a capsule is a dense and well-defined polymer layer surrounding the cell. Both capsules and slime layers are essential for the adherence of microorganisms and subsequent colonization, but they differ in some of their properties.
Difference between capsule and slime layers
| Properties | Capsule | Slime Layer |
|---|---|---|
| Organization | In capsule, polysaccharide layer is organized in a tight matrix that excludes small particles, such as India ink; it is called a capsule | In slime layer, polysaccharide layer is more easily deformed, do not exclude particles and is more difficult to see. |
| Adherence | Capsules typically adhere firmly to the cell wall, and some are even covalently linked to peptidoglycan | Slime layers, by contrast, are loosely attached and can be lost from the cell surface. |
| Role in pathogenesis | Capsule of pathogenic Escherichia coli promotes adherence to the brush border of intestinal microvilli. | Dextran slime layer of Streptococcus mutans promotes binding to tooth surfaces. |
Importance of Bacterial Capsule
Virulence determinants
Capsules are anti-phagocytic. They limit the ability of phagocytes to engulf the bacteria. The capsule’s smooth nature and negative charge prevent the phagocyte from adhering to and engulfing the bacterial cell. If pathogenic bacteria lose capsules (by mutation), they won’t be able to cause disease (i.e. loses disease-causing capacity). Polysaccharide capsule is the major virulence factor for Streptococcus pneumonia. Encapsulated strains of S. pneumoniae grow in lung tissues in enormous numbers, where they initiate host responses that lead to pneumonia. Nonencapsulated strains are less pathogenic; they are quickly and efficiently ingested and destroyed by phagocytes via phagocytosis.

Saving engulfed bacteria from the action of neutrophil
Bacterial capsule prevents the direct access of lysosome contents with the bacterial cell, preventing their killing.
Prevention of complement-mediated bacterial cell lysis
Capsule of gram-positive bacteria such as S*. pneumoniae* prevents interaction between C3b deposited on the bacterial membrane and the CR1 on phagocytic cells.
Protection of anaerobes from oxygen toxicity
Identification of bacteria
- Using specific antiserum against capsular polysaccharide. Â E.g. Quellung reaction.
- Colony characteristics in culture media: Bacteria with capsules form smooth (S) colonies while those without capsules form rough (R) colonies. A given bacterial species may undergo a phenomenon called S-R variation, whereby the cell loses the ability to form a capsule. Some capsules are very large and absorb water; bacteria with this type of capsule (e.g., Klebsiella pneumoniae) form mucoid (M) colonies.

Development of Vaccines
Capsular polysaccharides are used as antigens in certain vaccines. For examples:
- Polyvalent (23 serotypes) polysaccharide vaccine of Streptococcus pneumoniae.
- Polyvalent (4 serotypes) vaccine of Neisseria meningitidis.
- A monovalent vaccine made up of capsular material from Haemophilus influenzae.
Initiation of infection
Capsules help the organism adhere to host cells. The capsule also facilitates and maintains bacterial colonization of biological (e.g. teeth) and inanimate (e.g. prosthetic heart valves) surfaces through the formation of biofilms.
Capsule also acts as receptors forbacteriophages
Examples of Capsulated bacteria/yeasts
Mnemonicsto remember capsulated bacteria**– SomeKillersHavePrettyNiceC**apsule
- Streptococcus pneumoniae
- Klebsiella pneumoniae
- Haemophilus influenzae
- Pseudomonas aeruginosa
- Neisseria meningitidis
- Cryptococcus neoformans
Compositions of capsules of capsulated organisms
Note: Histoplasma capsulatum is not a capsulated fungi.
| Capsulated organism | Nature of capsule |
|---|---|
| Acinetobacter baumannii | Polysaaccharide |
| Streptococcus pneumoniae (pneumococcus) | Polysaccharide |
| Neisseria meningitidis (meningococcus) | Polysaccharide |
| Haemophilus influenzae | Polysaccharide |
| Klebsiella pneumoniae | Polysaccharide |
| Pseudomonas aeruginosa | Polysaccharide |
| Bacteriodes fragilis | Polysaccharide |
| Bacillus anthracis | Polypeptide (glutamate) |
| Streptococcus pyogenes (some strain) | Hyaluronic acid |
| Capsulated Fungi | |
| Cryptococcus neoformans | Polysaccharide |
References and further reading
- Bacterial capsules. (1990). Current topics in microbiology and immunology, 150, 1–162.
- Yoshida, K., Matsumoto, T., Tateda, K., Uchida, K., Tsujimoto, S., & Yamaguchi, K. (2000). Role of bacterial capsule in local and systemic inflammatory responses of mice during pulmonary infection with Klebsiella pneumoniae. Journal of medical microbiology, 49(11), 1003–1010. https://doi.org/10.1099/0022-1317-49-11-1003
- Forbes, S., Sahm, D. F., & Weissfeld, A. S. (2002). Bailey & Scott’s Diagnostic Microbiology. Mosby.